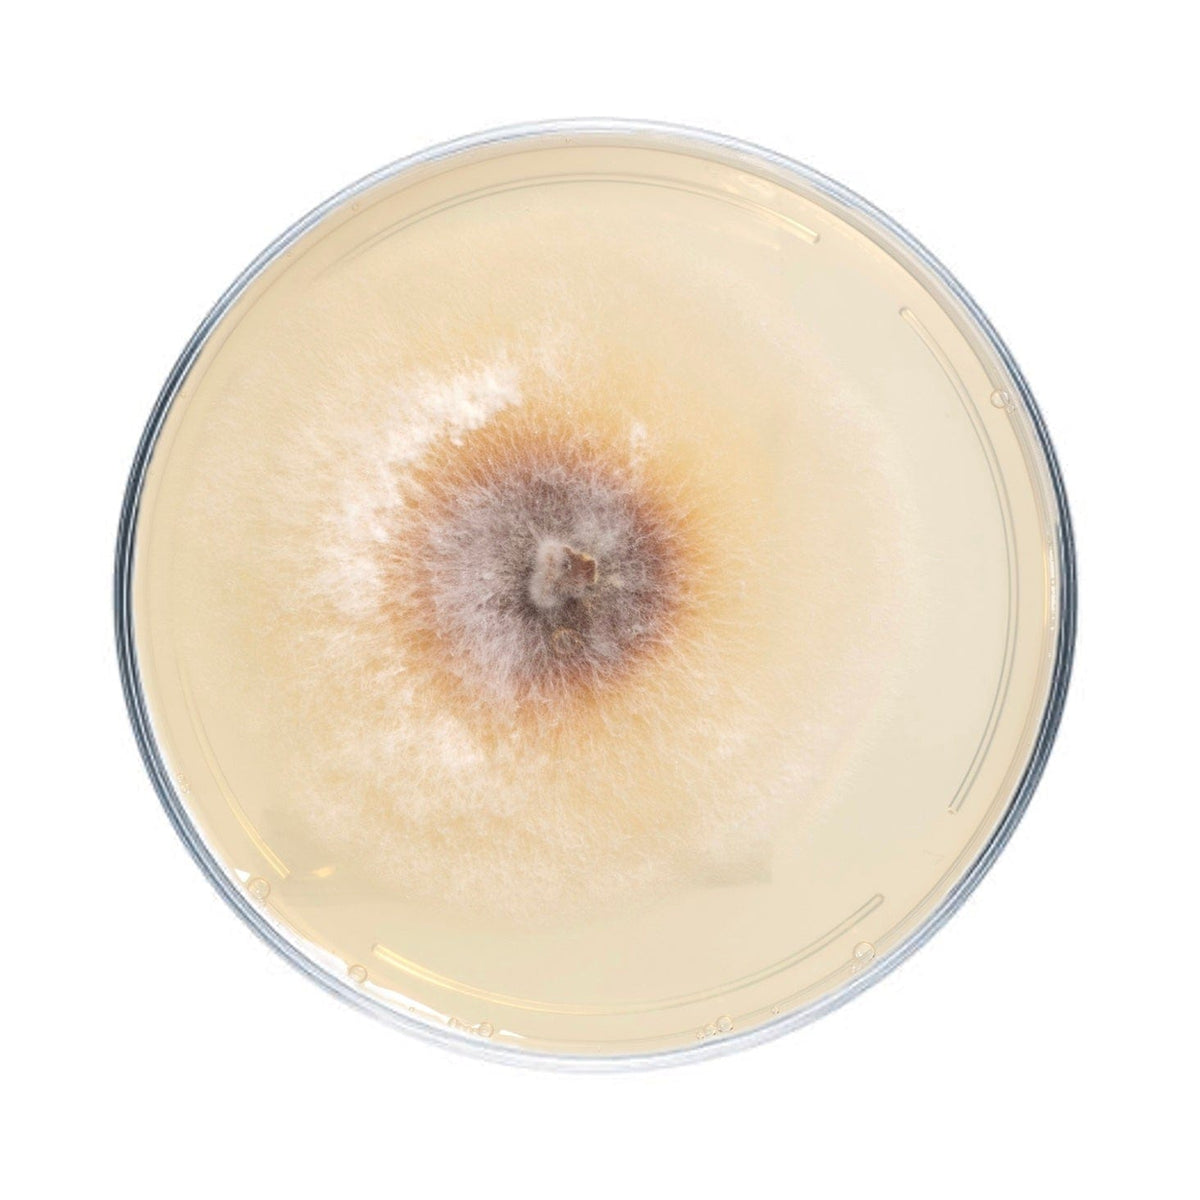
Culture Chaga Mushroom Agar Plate Culture

Chaga Mushroom Plate Culture
NSIO1 - ME Chaga (Inonnotus obliquus)
$74.99
Culture plates are ideal for growers looking to make master bags, inoculate grain, make liquid culture, or make more plates.
Chaga culture plates are made to order and have a shelf life of approximately 6 months. They should be stored in the refrigerator to maintain viability. Note that mycelium cultures require basic lab skills. Handle using sterile technique to prevent contamination.
See full description of each chaga strain available below.
NSI01 - ME Chaga
Inonnotus obliquus. Cultured from wild sclerotia in Maine. Chaga is an ancient medicinal fungus found primarily on birch in Siberia and Northern America, particularly in Maine in the US. Traditionally ground up and brewed into tea.
Frequently Asked Questions